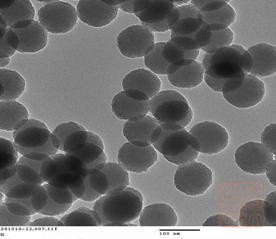

一、《国家文物博物馆事业发展“十二五”规划》编制研究 课题性质:国家文物局委托重点战略研究课题 课题/项目负责人:柴晓明 参加人员:沈阳、彭跃辉、于冰、郑子良、梁宏刚、党志刚、王晶、范佳翎。 起止时间:2010年1月—2010年12月 该课题在评估“十一五”时期国家文物博物馆事业发展的新成就、新经验及存在问题的基础上,研究制订了“十二五”时期国家文物博物馆事业发展的指导思想、基本原则、发展目标、主要任务、重大项目和措施,为完成《国家文物博物馆事业发展“十二五”规划》的编制工作奠定了坚实基础。

二、《中国文化遗产研究院“十二五”事业发展规划》编制研究 课题/项目负责人:柴晓明 参加人员:沈阳、李春玲、刘爱河、王晶 起止时间:2010年7月—2011年7月 该《规划》编制与研究工作紧紧围绕国家文化遗产事业的发展需求,对文研院目前存在的主要问题和面临的发展形势做了深入准确分析,明确了“十二五”期间发展的指导思想和基本原则,在实事求是的基础上提出未来5年发展的总体目标、阶段性目标和主要指标,明确了重点发展方向和主要任务,并提出必要的保障措施。该《规划》既体现了文研院的发展轨迹,也顺应了国家对事业单位、科研机构的新要求和新期待,凝聚了院领导班子和全院职工的集体智慧。

三、空间信息技术在大遗址?;ぶ械挠τ醚芯?以京杭大运河为例) 课题性质:国家科技支撑计划项目 课题/项目负责人:孟宪民 参加人员:于冰、乔梁、李宏松、丁见祥、赵夏、许凡、范佳翎、葛川、黄玉琴等。 合作单位:北京市文物研究所、天津市文化遗产?;ぶ行?、河北省文物?;ぶ行?、山东省文物考古研究所、南京博物院、浙江省文物考古研究所、东南大学等。 起止时间:2006年12月—2010年6月 我院作为第二承担单位,与清华大学、中科院遥感应用研究所、中国水利水电科学研究院四家单位共同合作执行。我院主要承担了“大遗址?;た占湫畔⒓际跤τ眯枨蠓治觥薄ⅰ熬┖即笤撕酉肿吹鞑橛肟占涫莶杉?、“京杭大运河遗产历史文化与当代人居环境研究(以扬州为例)”等三项专题的研究和组织工作。

课题组完成了大运河现场调查、需求分析、数据采集等基础性工作,提出了京杭运河?;す婊嘀朴肭ㄒ?,同时完成了《大遗址保护空间信息技术需求分析总报告》等5份研究报告及《京杭大运河现状调查与信息采集工作导则》等5项规范;出版《大遗址?;だ砺塾胧导奶剿鳌?、《汶上南旺——京杭大运河南旺分水枢纽工程及龙王庙古建筑群调查与发掘报告》2本专著;发表《京杭大运河遗产的特性与核心构成》等4篇论文。2010年4月,课题通过科技部论证并结项。
四、石窟岩体结构稳定性分析评价系统研究 课题性质:国家科技支撑计划项目 课题/项目负责人:王金华 参加人员:张兵峰、李黎、刘建辉等。 合作单位:中国地质大学(武汉)、中国科学院武汉岩土力学研究所、中国水利水电科学研究院、云冈石窟研究院 起止时间:2009年9月—2011年12月 该课题以云冈石窟为研究对象,研究内容包括云冈石窟形制机构和石窟岩体调查,构建云冈石窟地质模型与简约力学模型,开展环境温度及岩体梯度温度检测、岩体含盐量分析及分布研究、岩体风化影响因素及环境作用长效劣化试验研究等各种流变场的耦合分析,建立石窟岩体稳定性影响指标体系,并根据石窟岩体的破坏形式和状况,建立不同状况的石窟岩体稳定性评价体系。

2010年课题完成了云冈石窟病害调查工作,并取岩样进行室内实验。同时开展了崖壁岩体结构、石窟岩体卸荷带、不同部位岩体微观结构成分分析及分布规律、岩石风化分布特点及指标、岩石中盐类分布分析等项研究工作,完成了《云冈石窟病害调查分析报告》,并对云冈石窟病害,特别是可能影响石窟危岩体发育的岩体开裂、表面风化、可溶盐、渗水等方面的问题作了全面的调查和分析。 五、无损或微损检测技术在石窟?;ぶ械挠τ醚芯?br> 课题性质:国家科技支撑计划项目 课题/项目负责人:高峰 参加人员:周霄、胡源、孙延忠、葛琴雅、王志良、郭宏 、成倩等。 合作单位:山西大同大学、中国地质大学(北京)、南开大学、云冈石窟研究院、中国科学院微生物研究所、武汉大学 起止时间:2009年9月—2011年12月

该课题以云冈石窟为主要研究对象,以石质文物表层风化、裂隙病害无损或微损检测技术研究为重点,从病害表观现象与微观特征关系入手,研究风化病害表征指标,通过现场无损、微损分析检测以及实验室大型仪器取样分析测试,结合标准模型、数据校正、系统方法分析等手段,开展石质文物表层风化和表层裂隙无损或微损检测技术方法研究,确立云冈石窟石质文物表层风化无损或微损检测方法、表层裂隙无损或微损综合探测方法、石窟表层污染物综合无损探测技术与操作规范以及石窟风化层状况综合无损探测技术与操作规范。 2010年课题完成国内外前期资料调研工作,完成《砂岩风化指标的探索研究》等5篇文献综述,完成各种无损技术方法与仪器的评价和筛选工作,完成现场勘查、选点及采样工作,并开展现场原位分析的预实验。课题已培养硕士研究生1名,完成学位论文1篇,欧洲地球学会会议接受论文4篇。
六、南京报恩寺阿育王塔及出土文物保护技术研究 课题性质:国家科技支撑计划项目 课题/项目负责人:马清林 参加人员:张治国、沈大娲、宋燕等。 起止时间:2009年9月—2011年12月

该课题为国家科技支撑计划课题《南京报恩寺遗址地宫及出土文物?;ぜ际跹芯俊分械闹匾蒲腥挝???翁庋芯恐饕拱⒂跛撒探鹨魑锉;ぜ际酢⒊鐾凉探岱闹酚胗』娣闹繁;ぜ际?、出土香料?;ぜ际?、出土玻璃器?;ぜ际醯确矫娴难芯?,同时开展?;な痉豆ぷ?,研究并制定阿育王塔及出土文物保护方案。 2010年课题完成国内外鎏金银器、玻璃器、香料、固结及印绘纺织品分析与?;は喙匚南缀妥柿系牟樵?、整理与研究工作;开展了阿育王塔鎏金银病害调查、木胎变形调查及样品采集、纺织品病害调查和样品采集工作,并对银鎏金文物、玻璃器、宝石、香料、纺织品等文物开展无损检测;完成阿育王塔鎏金表面?;ご砉ぷ骱脱贩治黾觳庥氡;げ牧鲜匝檠芯抗ぷ?。
七、环境因素控制下的砂岩类文物材料性能失效分析研究 课题性质:国家自然科学基金项目 课题/项目负责人:李宏松 参加人员:张金风、吴育华、高峰、孙延忠、周霄等。 合作单位:云冈石窟研究院、上海德赛堡建筑材料有限公司、同济大学、合肥学院 起止时间:2008年1月—2010年12月

课题通过开展“砂岩类文物材料”性能失效特征和评价体系研究,研究单一环境因素影响下“砂岩类文物材料”性能失效的模拟与评价研究、综合环境因素影响下“砂岩类文物材料”性能失效模拟与评价研究、我国不同环境下防止“砂岩类文物材料”性能失效的?;ざ圆哐芯康然±砺畚侍猓ⅰ吧把依辔奈锊牧稀毙阅苁卣?、指标体系和评判标准,提出环境因素控制下“砂岩类文物材料” 性能失效分析与评价方法,以及我国不同环境下防止“砂岩类文物材料”性能失效的?;ざ圆吆脱芯糠较颉?br> 2010年完成课题相关试验,并完成部分数据的整理、研究报告2份,发表《世界文化遗产云冈石窟石雕科学?;さ募际跸拗啤返?篇论文,另完成《文物岩石材料劣化形态分类研究及应用》等7篇论文(待刊发)。 八、溶液-凝胶法制备负载缓蚀剂的有机化涂层及其在铁质文物?;ぶ械挠τ醚芯?br> 课题性质:国家自然科学基金青年基金项目 课题/项目负责人:沈大娲 参加人员:张治国、田兴玲、马清林等。 合作单位:天津工业大学、国家博物馆 起止时间:2010年1月——2012年12月
课题组在对铁质文物腐蚀机理及?;し椒ㄗ芙岬幕∩?,针对文物?;さ那惺敌枨螅杓普攵蕴饰奈锔刺氐愕耐坎悴牧?。 2010年,课题按照计划进展,已经初步完成材料制备方法的研究工作。
九、文化遗产领域公共文化服务体系研究 课题性质:国家社会科学基金国家青年项目 课题/项目负责人:彭跃辉 参加人员:党志刚 起止时间:2010月9月—2012年12月

课题以实证研究为基础,评估文化遗产领域公共文化服务体系的发展现状,研究文化遗产领域公共文化服务体系的基本构成,探讨文化遗产领域公共文化服务体系建设的发展方式和路径选择,为构建文化遗产保护成果惠及民众的基本途径、形成文化遗产?;と谌刖蒙缁岱⒄沟某ばЩ?、建设公共服务型政府提出政策建议和立法建议。 2010年课题完成了资料文献收集整理,并细化研究方案。
十、文物术语研究 课题性质:国家质检总局质检公益性行业科研专项 课题/项目负责人:乔梁、张廷皓 参加人员:詹长法、何流、李宏松、王乐乐、程博等。 起止时间:2006年-2010年

该课题通过对现行有关术语的收集、梳理和甄别,并从行业特点出发,结合现相关国际和国家标准,对文物领域概念体系、文物术语的使用范围及界定标准进行研究,提出术语标准化基本原则和编制方法,探索文物领域的术语体系。 该课题已基本完成,待结项。 十一、清代建筑世家样式雷族谱校释 课题性质:国家清史编纂委员会文献类课题 课题/项目负责人:崔 勇 参加人员:易 晴(中国艺术研究院) 起止时间:2007年10月—2010年12月 “样式雷”在清代建筑史上具有举足轻重的历史地位,《雷氏族谱》记录雷氏家族七代人数百年间运转历程的来龙去脉,是清代历史的映照,为清史编修的重要参考。目前《清代建筑世家样式雷族谱校释》(共30万字)研究工作已如期顺利完成,并于2010年12月通过国家清史编纂委员会专家评审结项。在项目执行期间,课题组发表论文《清代建筑美学历史总结——清代建筑世家样式雷族谱及图档研究综述》一篇以及调研报告《清代建筑世家样式雷家族与族谱史?!肺迤?br>

|